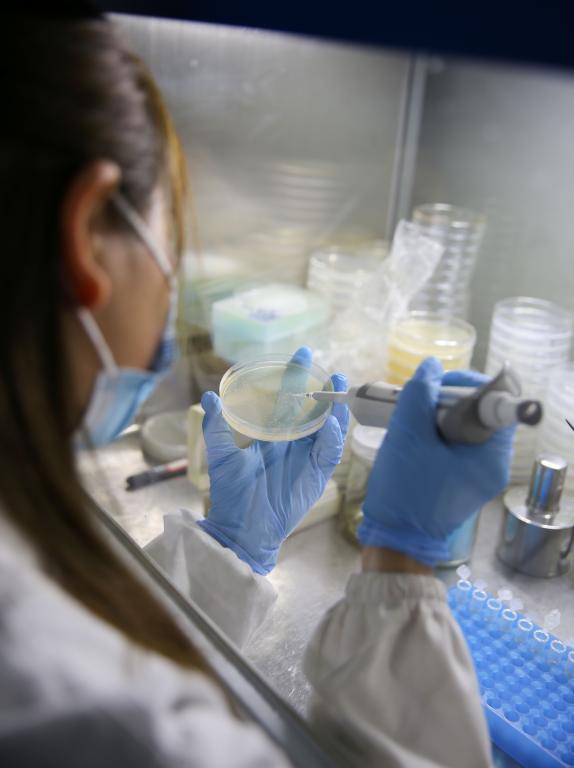

劳动铸就梦想,奋斗书写精彩。在校园的每一个角落,湖北中医药大学的劳动者坚守岗位,默默付出,用双手创造美好,用汗水浇灌希望。今天,校园网记者带您走进节日中的湖北中医药大学,一起定格感悟劳动之美。
谢谢您,老师们
站稳三尺教堂 传道授业
循循善诱 如春风化雨
将知识毫无保留地传递 用智慧指引我们前行


辅导员们
深入课堂 走访寝室
与同学们同劳动 共锻炼
春去秋来 用心用情守护好每一位学生



宿管员们
天冷了 提醒我们加衣
下雨了 帮我们收好衣物
晚归时 为我们留下一盏明灯
日夜守护 只为给予我们家的温暖



还有你们
不惧风雨 无畏烈日
从清晨到深夜 守卫巡逻
筑牢校园第一道“防线”



后勤人员
是校园“美容师”
与落叶为友 与尘埃为伴
用勤劳的双手
换来干净整洁的校园



在食堂忙碌的你们
带来一日三餐的温暖
看到大家吃得开心 吃得健康
就是最大的幸福



医护人员
或身穿白大褂 或身着防护服
坚守在一轮轮核酸检测一线
守候在一张张诊疗台前
为师生身体健康保驾护航


图书管理员
一次次整理书籍
让每一本图书都回到整齐的书架
为读者带来充满书香的假期

志愿者们
身披红马甲 佩戴红袖章
穿梭在教学楼 食堂 核酸检测处
分发口罩 维持秩序 协助采集
构成了校园靓丽风景


我们更要向逆行的你们致敬!
不畏艰险 冲锋在前
迎难而上 逆行远征
日夜奋战 守护人民安危


学子们正在传承你们的仁心仁术
在附属医院内
他们跟随导师抄方 查房
日日早出晚归
忙碌且充实


实验室里 争分夺秒 火力全开
图书馆里 畅游书海 细品墨香
运动场上 趣味游戏 挥洒汗水

深耕细微处 微末见真章
在这个属于劳动者的日子里
让我们致敬
每一位踔厉奋发的湖北中医药大学人
致敬为梦想奋斗的你我
(文字:陈依 胡梦佳 摄影:大学生记者团 牛子薇 周爽 杨沁瑜 易佳盈 张欣怡 部分图片由中医临床学院 第一临床学院 针灸骨伤学院 药学院 学生工作部 保卫处 后勤管理处、后勤集团 图书馆提供)